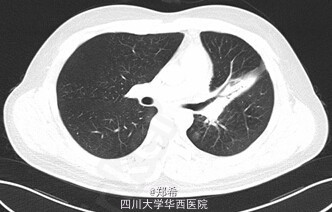
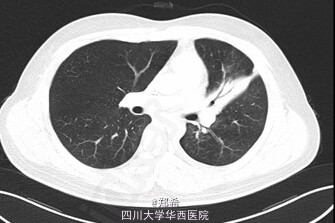

下载或打开 医联APP 查看完整评论
立即下载
打开APP
患者21岁,因“咳嗽、咳痰1+年”入院。患者于1+年前无明显诱因出现咳嗽、咳痰,咳黄色脓痰,量少,伴潮热盗汗,于当地医院住院治疗,活检示:支气管内膜结核(具体报告未见),遂予一线抗结核药物治疗,半年后于我院呼吸内科住院调整为二线抗结核药。6+月前因“支气管结核狭窄”于外院安置左主支气管支架,后多次于复查纤支镜取支气管支架均未取出,并于我院查TB-DNA阴性。于1-月前查胸部增强CT示:左肺上叶舌段实变肺不张,作肺内散在斑片条索影,左主支气管内见高密度支架影,支架内可见少许软组织密度影,其远端左主支气管管壁稍厚,多系炎症;左肺门淋巴结增大;心包少量积液;左侧胸膜增厚,左侧胸腔少量积液。查体:左肺呼吸音低。初步诊断:1、左主支气管狭窄2、左主支气管支架置入术后3、支气管内膜结核4、糖尿病。处理:全麻下行左主支气管支架取出+左全肺切除术。手术顺利,术后入ICU继续治疗。讨论:肺结核最严重的并发症之一就是能够引起支气管狭窄,支气管胸膜瘘,因此,要按照结核治疗标准早期、规律、全程、联合用药,此病例属于典型结核引起支气管狭窄,最后不得不切除全肺。